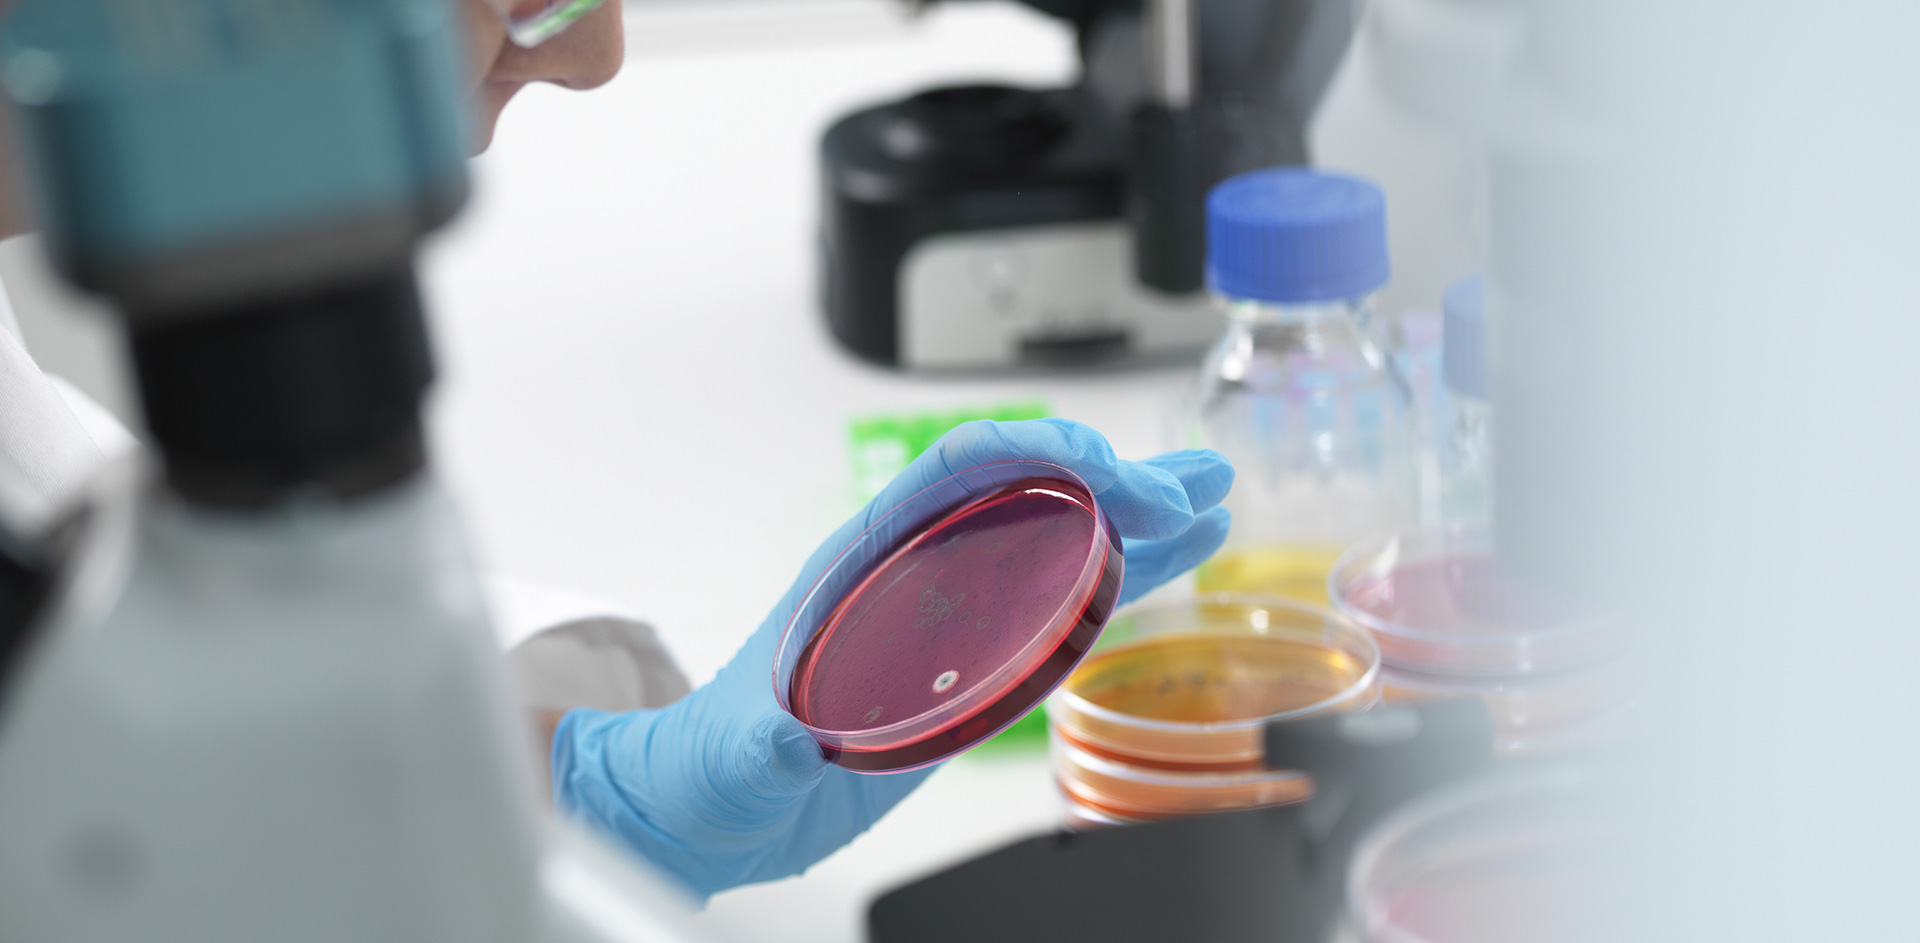
Live Cell Analysis

Live cell analysis, also known as live-cell imaging, is the real-time study of dynamic biological processes in living cells, made possible by microscopy techniques combined with the use of advanced software.
How does live cell analysis work?
Live cell analysis provides detailed information on cell function and health, overcoming the limitations of techniques that provide a static snapshot, such as flow cytometry or PCR, which analyse samples at a single specific moment in time. The techniques used include monitoring migration, proliferation and viability, often without labelling, to preserve cell viability and allow multi-stage analysis. It also uses time-lapse microscopy to acquire images and videos of the analysed cells over time, as well as fluorescent proteins, microscopy and analysis software.
However, it should also be noted that the use of fluorescent dyes is not always optimal, as it can be invasive and alter the results. Therefore, in these cases, it is advisable to use techniques such as “StainFree” technology or real-time impedance, which preserves cell viability so that subsequent analyses can be performed on the same cells.
Live cell analysis: an Italian-Dutch in vivo study
An interesting in vivo study published in the journal PNAS (Proceedings of the National Academy of Science) by researchers at the University of Milan, in collaboration with Radboud University Medical Centre in the Netherlands, has shown how collective invasion of the dermis by tumour cells occurs “in vivo”.
It has long been known that cells are capable of moving individually or in groups, but until now, studies have mostly been conducted in vitro. Therefore, they started from the observation that 90% of cancer deaths are related to metastases, secondary tumours that form at a distance from the initial tumour, originating from diseased cells of the primary tumour that have migrated. It is therefore essential to understand the mechanisms underlying this migration in order to identify new strategies for treating metastases.
The researchers used live cell analysis implemented using intravitreal multiphoton microscopy.
Through this technique, which allows 3D image reconstruction by observing tissues at different resolutions and focal planes, it has emerged that cells use a multicellular migration mode, moving in a loosely cohesive and turbulent manner, which self-organises into persistent alternating paths, where cells move back and forth from the original tumour, using interstices that are already present in the tissues.
From these observations, it was highlighted how cells make their way through tissues by compressing them, highlighting that the presence of tissue capable of enclosing and compressing the tumour plays a central role in both the movement and organisation of the tumour cells themselves. It was also seen that the collective migration of tumour cells occurs via the pathways exploited by the T lymphocytes of the human immune system.
Live cell analysis: its undeniable advantages
Monitoring live cells opens up new perspectives for research not only into diseases and their evolution, but also into the development of personalised drugs and therapies, as well as opening up new scenarios in the fields of biology and genetics.
The dynamic data obtained in this way also allows us to see the evolution of cells over time, rather than simply “freezing” them at the moment of analysis in terms of their cytoarchitecture or state. It also saves time and resources compared to protocols that require fixation and staining, as multiple analyses can be performed on viable samples.
All this makes it possible to combine images (i.e. qualitative data) with cell mass measurement or cell counting (i.e. quantitative data) in order to better understand cellular processes.
Want to learn more?
Browse our full catalogue here to explore products that support live cell analysis, cell culture, and advanced laboratory research.
Sources
O. Chepizhko, J. Armengol-Collado, S. Alexander, E. Wagena, B. Weigelin, L. Giomi, P. Friedl, S. Zapperi, & C.A.M. La Porta, Confined cell migration along extracellular matrix space in vivo, Proc. Natl. Acad. Sci. U.S.A. 122 (1) e2414009121, https://doi.org/10.1073/pnas.2414009121 (2025).